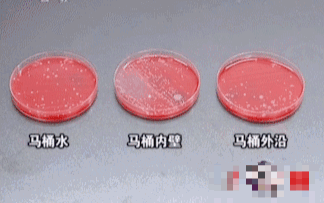

懒人看过来!马桶清洁神器,用它喷一喷,5分钟解决细菌、污垢~再也不用刷马桶!
谁能逃过干家务的活
垃圾污渍不会自己飞走
想想工作已经够累人的了
回家还要做家务
瞬间心情低落了

尤其是清理卫生间
自己一个人住要是每天勤快点
马桶也不会脏到哪里去
稍微刷刷杀杀菌就可

可怕的是一大家子人
就你承担着清理的重任
每次刷马桶都能被恶心到
又臭又脏,根本不想碰

而且问问大家,有谁
刷完马桶还会特意清洁一下刷子
有时候马桶刷干净了
刷子上的細菌照样满天飞

如果马桶看着挺干净
鼻子却总是能闻到一股骚臭味
其实也很大可能就是
马桶刷“惹的祸”

不管你马桶刷的多干净
上完厕所,总会有屎尿
被气旋冲出来四处飞溅
各种細菌垃圾四射

細菌飞到牙刷上,毛巾上
洗手台,天花板上
想想每天用这牙刷刷牙
用这毛巾擦脸,真的头皮发麻

不仅如此,这些細菌中
含有50多种致病細菌
家里要是有老人和小孩
免疫力低,很容易影响身体健康
有时候突如其来的发热
庠痛红包,呕吐拉肚子,妇科炎症
可能都是因为这些有害菌入侵
注重家庭健康的人
一定要把卫生间清理干净

为了让厕所更干净
平日里洁厕产品真是没少买
费钱不说,还没一个好用的
到头来还是只能将就着
自己慢慢清理厕所

有没有省时省力省钱的办法
给大家推荐这款亲身试用的
DDOXOO马桶洁厕泡泡
一喷一冲,污垢細菌全不见
360°清洁去垢,解放双手

和传统的液体清洁剂不同
这款喷出来就是细腻泡泡
可以大面积覆盖污渍地区
阻隔污渍与外界环境

静置几分钟,污渍自己溶解
肉眼可见的干净
清理马桶再也不麻烦
再也不用烦恼清理马桶了

不仅仅是清洁马桶
洗手池,水龙头,浴室瓷砖
哪里脏就喷哪里
帮你一键换新浴室

效果好大家都看得见
这款马桶清洁泡泡慕斯
上市以来,已经卖爆了
再也不用手刷马桶,懒人必备


1
说起刷马桶,很多人估计
就一个反应:恶心
就算马桶看着挺白净
想想天天和屎尿接触过
也真是一点不想动
尤其是一段时间没清理马桶
从里到外都是尿垢,便渍、细菌
在家里就算隔着房间离得很远
都能闻到马桶若有似无的臭味
实在太恶心了,这活真干不下去了
而这款马桶泡泡清洁慕斯
完全颠覆之前对洁厕产品的印象
轻轻一喷就能看到绵密的泡沫
云朵般绵柔,看着就赏心悦目

清洁能力更是不容小觑
喷完静置几分钟
就能看见黄垢杂质都溶解
一冲水,污渍都带走
就连平常刷不到的死角都干净了

不只是表面,特别添加
渗透剂,可以渗透壁面内部
分解污渍,深层洁净

遇到那种陈年老黄垢
让泡沫在马桶壁上
多附着一段时间
再配合马桶刷,刷一刷
水一冲,轻松白到发亮

活性成分,遇水后分子破裂
分解出氧分子并迅速膨胀发泡
把附着在物体上的污垢溶成小分子
从而起到清洁除垢的作用

冲的泡泡水流向管道
还能起到清洁管道的作用
管道干净了,冲水顺畅了
告别管道恶臭
再也不用担心厕所异味

而且不仅仅是管道马桶
一个卫生间几乎都能清洁
洗脸池,浴缸,瓷砖,水龙头
轻轻一喷,整个卫生间都干净了

清理浴室瓷砖很麻烦
但是有了这款马桶泡泡
喷一喷,冲一冲,污渍都带走
再也不用烦恼清洁问题

还有家里的玻璃门
窗户,镜面,平常擦洗很累
每次清理好感觉腰都要断了
用这款慕斯一喷一擦就搞定
简直不要太省事了

温和清洁,无腐蚀,不刺激
不会损坏马桶洗手池釉面,安心使用
让卫生间的边边角角都干净

这么好用的马桶泡泡
可以说是懒人之光了
家中常备,让洁厕更轻松
不费力就能保持卫生间干净状态
简直不要太舒服

2
作为一款能够漂洋过海的清洁剂
它背后的来历也确实硬核
美国品牌DDOXOO
拥有属于自己的生物实验室

23年专研清洁产品
在家庭清洁这方面
可以说是“行业佼佼者”
口碑一直不错

进口货物海关报关单
正规来源,正品保障
放心购买使用

而且产品还通过了
国内相关机构的质检
符合国家的相关规定
让你用的更安心

用它不仅能清洁马桶
还能在马桶内壁形成保护膜
防止細菌和污垢的粘附
让马桶长久保持干净卫生

有了这款马桶泡泡
再也不用面对臭味和屎尿垢
每次上厕所都是一种享受
大大提升生活的幸福感

3
这款马桶泡泡清洁慕斯
还有一个优点就是自带淡雅清香
不像传统的洁厕剂一股异味
清洁卫生间的时候芳香四溢
刷马桶都不会有恶心感

上厕所的时候一喷
花香点缀着清香
告别刺鼻气味和酸臭
比空气清新剂还好用

它使用很简单,拿到手
轻微摇晃并旋转喷头
直接对准污渍处喷洒
静置一段时间冲水即可

特别设计了可倒喷装置
360°无死角,缝隙也能喷到
让居家清洁更加方便

不管是蹲厕、马桶、小便池,
亦或是浴缸,洗手池
瓷砖、地板等,适用范围广
可以解决多个场所卫生问题

每瓶足足650g,保质期5年
一拿到手就能感觉到十足的分量
每天用都能用好久
注意不能与含氯产品混用

我们给大家争取到了超值福利
不管是自己用还是买给家里
都能趁着活动多囤上几瓶,很划算
有了它再也不用哼哧哼哧刷马桶
一喷一冲,除臭清洁,方便快捷


夜雨聆风